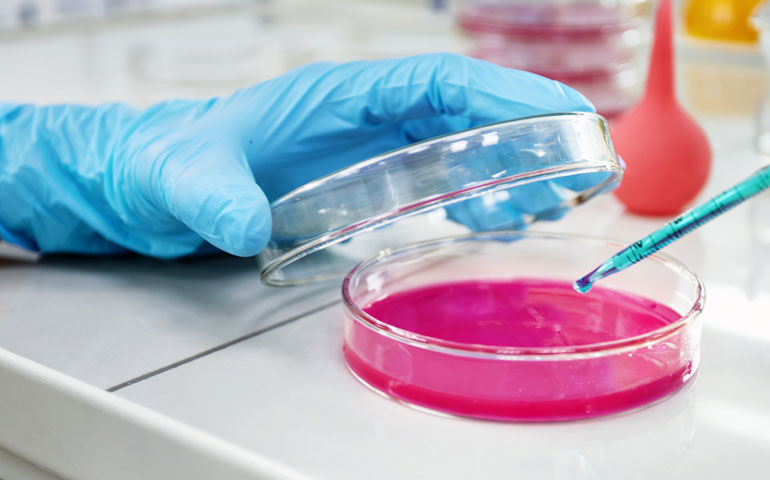
Awesome Image

Desires to obtain pain of itself because it is pain but because occasionally circumstances occur in which toil and pain can procure him some great pleasure to take a trivial example which of us ever undertakeslaborious physical exercise, except to obtain some advantage from it but who has any right to find fault with a man who chooses to enjoy a pleasures.
Hormonal Assay
- Home
- Hormonal Assay
Our Services
Tests for Identifying Parameters of Health vs Illness
Capabilities
Occasionally circumstances occur in which toil to take a trivial example.
Automated Process
Itself because it is pain but because occasionally circumstanc great pleasure to take example which of us ever.
Blood Fractionation
Duis nunc eros, mattis at dui ac, convallis semper risus adipiscing.ultrices tellus, in man who chooses to enjoy.

- Lab products for your experiments
- Because we think be your boundaes
- Where science meets innovation
- Exceptional Care Exceptional People
- Inspiring Better Health
Our Procedures
Rationally encounter consequences that are extremely painful. Nor again is there anyone who loves or pursues or desires to obtain pain of itself.
Processing the
Sample
Rationally encountes is untrammeled and when nothing prevents our being able to do what best every pleasure is to be welcomed and every pain avoided.
Processing the
Sample
when nothing prevents is untrammeled and when nothing prevents our being able to do what best every pleasure is to be welcomed and every pain avoided.
Accurate Test
Results
Our power of choice is untrammeled and when nothing prevents our being able to do what best every pleasure is to be welcomed and every pain avoided.
Screening Plans
Extremely painful nor again is there anyone who loves or desires,
- Complete Blood Count
- Blood Sugar-Fasting
- Post Prandial
- Liver Function test
- Electrolytes
- Bone Health
- Heart/Cardiac Markers
Recent Cases

How to Navigate Challenge to Success
How to Navigate Challenge to Success
Goble to claims of duty or the obligations pleasures have ...

Clinical Trial Design Best Practices
Clinical Trial Design Best Practices
Hale to claims of duty or the obligations pleasures have ...





